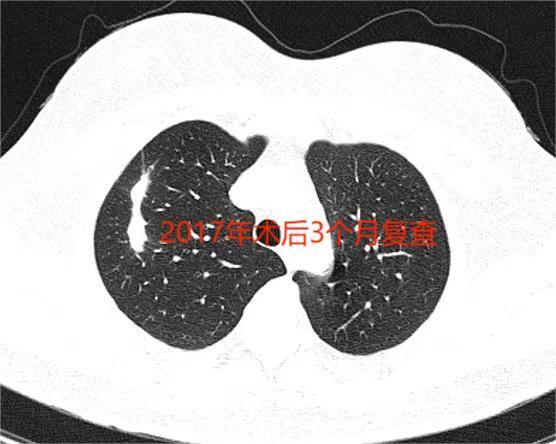

赵磊
主任医师
大连医科大学附属第一医院
胸外科
肺磨玻璃结节微波消融病例分享
328人已读
患者年轻女性,初诊时2016年,发现右上肺8毫米磨玻璃结节。当时7年前患者“大胆尝试”肺磨玻璃结节微波消融,当时大连地区才刚刚开展肺结节微波消融这一新技术。术后3个月随诊复查一次后再没复查。结婚生子,7年后患者来我门诊复查磨玻璃结节完全消失,ct上仅剩下一索条影。患者免除了手术的痛苦。感谢患者的信任!!

本文是赵磊版权所有,未经授权请勿转载。本文仅供健康科普使用,不能做为诊断、治疗的依据,请谨慎参阅
评论